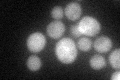
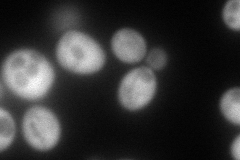
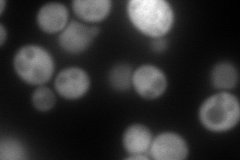
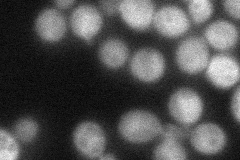

View description
Uroporphyrinogen decarboxylase, catalyzes the fifth step in the heme biosynthetic pathway; localizes to both the cytoplasm and nucleus; a hem12 mutant has phenotypes similar to patients with porphyria cutanea tarda
Localization:
Intensity:
Fold change:
Significance:
-
C’ GFP library in SD
cytosol40.15 -
N' NOP1pr-GFP in SD
cytosol176.372 -
N' TEF2pr-mCherry in SD
cytosol291.22 -
N' NATIVEpr-GFP in SD
cytosol56.2839 -
N' TEF2pr-VC and Cyto-VN in SD

cytosol72.0557 -
C’ GFP library in SD+DTT

cytosol23.670.58Yes -
C’ GFP library in SD+H2O2

cytosol45.381.13No -
C’ GFP library in Starvation Media

cytosol70.681.75Yes -
C’ GFP library on the background of Pup2-DaMP

cytosol -
C’ GFP library on the background of CCT mutant

cytosol50.90541.26735No
